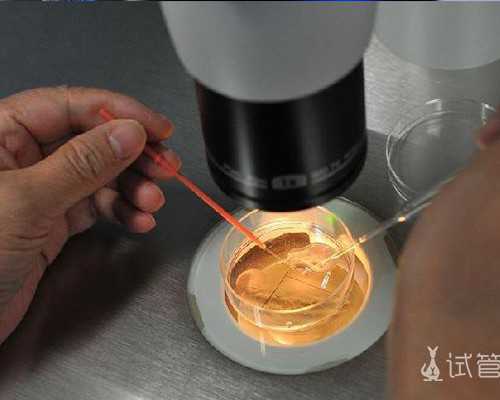
宝妈这样说:香港孕妈妈查血验性别多少钱?没错，只需2600!,怀孕去香港验血大约

宝妈这样说:香港孕妈妈查血验性别多少钱?没错,只需2600!那么可以提早的知道自己宝宝性别都有哪些办法呢?我们日子中经常听到的就是这几种了:看孕吐反应状况、看怀孕往后饭量的大小、通过B超猜想宝宝性别香港验血检测宝宝性别。这些办法中哪一种最准确呢?今天我们就来将这些办法彼此做一个比较。
香港验血准确性为什么那么高,其原理是什么?
孕妈妈的血液标本被抽出后,首要通过两次高速离心处理,将上层的清液移入新的无菌管内,冷冻保存备用。然后运用试剂将上清液中的DNA提取出来,将其染色,放在紫外灯下查询。假设看到SRY的条带意味着是男孩,没有则标明是女孩,而且伴随胎儿不断长大,DNA浓度还会越来越高。 这些DNA和胎儿性别之间终究有什么联络呢?原本,研究人员发现一种被称为“SRY”的基因只存在于Y染色体上,一旦检测到它的存在,便意味着胎儿是男性,所以分别出母亲血液中的胎儿DNA看看能不能找到SRY基因,性别疑问天然便利的处理。和B超要等到胎儿足够大时才华查询性别特征不同,这种检查在受孕后7周便可实行,而且准确率比B超高,可抵达99.8%。
DNA验性别优势在于:
1、时间早(只需孕妈妈怀孕经B超招认实践发育周抵达7周或以上就可以验),
2、断定的准确率达99.8%,香港依学界揭穿招认的断定准确率。
3、香港的依疗有确保,全部断定都会出具断定陈说原件。并有断定中心相关资料可以进行核实。
4、作业日抽血送检,断定效果最快隔天可以出来。
香港验血的价格
1、香港采样:预订直接过香港做7周查验4000港币(折合人民币3500),预订后有详细路途。
2、大陆邮寄样本:孕7周或以上大陆邮寄血样送检香港声威三大化验所4000人民币;
3、深圳协作诊所采样:预订深圳协作诊所采血,共4000人民币,预订后发您详细地址,到时直接导航即可。
最安全有效果的胎儿断定办法就是DNA母血断定,准确度可以达99.8%
香港验血查男女的原理
DNA片段和胎儿性别之间终究有什么联络呢?原本,研究人员发现一种被称为“SRY”的基因只存在于Y染色体上,一旦检测到它的存在,便意味着胎儿是男性,所以分别出母亲血液中的胎儿DNA看看能不能找到SRY 基因,性别疑问天然便利的处理。和B超要等到胎儿足够大时才华查询性别特征不同,这种检查办法在受孕后7周便可实行。
香港检测DNA的费用多少
香港检测DNA的费用多少?香港检测DNA的费用大概在4000港币左右。不是香港人的话,还要算上港澳通行证的费用,机票的费用,在香港的住宿费用我就没办法答复你了,因为每年的消费趋势都不相同。也可以深圳采血,我们当天送到香港化验检测。您假设不便利到深圳,我们邮寄专业医用设备给您,您可在当地采完血后寄顺丰到深圳,我们收到当天送到香港化验检测。
测男女需求孕几周才华进行断定。怀孕时最想了解宝宝的男女性别,因国内不允许做胎儿男女性别断定,而在香港可通过验血来检测性别断定的,来确定是生男生女,这也是现在最安全便利的办法,那生男生女香港验血检查男女怎么做?让我们一齐来了解下香港验血技术。
生男生女香港验血检查男女怎么做?
香港验血查男女的原理及优势:
香港验血查生男生女也叫Y-DNA染色体检测,该检测首要运用基因工程的技术,因人是由23对染色体组成,其中有一条性染色体抉择着人的性别。在妊娠期,胎宝宝的少量DNA会进入母亲的血液。
人是由X和Y染色体抉择性其他,认为而正常状况下,妈妈的染色体必定是XX。技术人员可以通过检测母亲血液中的DNA,假设发现有Y染色体的状况,那么就可以必定这位妈妈怀的是男孩了。
香港声威的化验所承受境内外检测化验作业,香港验血胎儿性别断定也是由该三家化验所供应检测陈说具有声威性,高准确性,高责顽固,化验师签字陈说具有法则效益。供应的香港验血效果并供应化验所网站及电话陈说查询,香港验血也支撑网上查询验证陈说真伪。
现香港验血价格非常实惠,一般化验陈说会在化验所收到血样后一个作业日内供应。在孕妈妈收到验血效果后,可能会觉得一张纸能看出什么,上面现已说过验血原理,验血就要是从母体血样中检测Y染色体的SRY基因。香港验血是根据SRY基因是Y-DNA染色体技术检查胎儿男女性别重要信息,如香港验血检测中如SRY基因那陈说中就会闪现有Y染色体存在,也就证明该胎儿为男宝宝,反之,为女宝宝。
怀孕后验血查性别其实跟着科技以及医疗的展开,这些问题早已不是问题,腹中胎儿的性别也早已不是隐秘。其时人们可以通过多种办法来检查腹中胎儿的性别,其只最盛行的就是香港验血。
这儿需求解释一下,香港验血并非是我们往常所说的那种验血,香港验血其实是DNA基因检测的代称。只是因为在做检测的时分会涉及到抽血查验,因此人们才用香港验血来代表Y-DNA基因检测。这种检测和我们往常去医院验血是完全不同的两种概念,因此在附近找个医院是不能结束的,因为Y-DNA检测的目的是为了断定孕期内胎儿的性别,这种断定胎儿性别的行为在国内的大陆地区是法则明令阻止的,也许是出于重男轻女这种传统观念的考虑吧。可是香港作为特别行政区,在法则制度上和大陆是有一些不同的,因此在香港并没有阻止这种断定行为,所以许多人在孕期想要知道胎儿的性别都会去香港进行DNA基因检测。
怀孕后验血查性别
其时香港最靠谱的检测安排就是香港时代基因检测中心,他们具有国际最先进优质的设备,精雕细镂的心情把国际一流的技术运用到科学研究以及临床实验中。全自动样本处理系统使得香港时代基因检测中心具有超强的标本处理才干,一同其全自动化的查验进程在无菌环境下进行,蒋化验进程中的污染问题将会减到最低。更令人定心的是,香港时代基因检测中心具有实力雄厚的专业团队,他们严厉实行优异实验室操作,确保每份化验陈说都可以准确,香港时代基因检测中心以最尖端的基因技术为中心,运用专利的DNA检测和分子确诊技术,胎儿Y-DNA检测、胎儿性别断定、亲子断定、无创产前DNA检测以及疫苗打针等服务。
做过香港验血检查的妈妈们都是很有慨叹的吧!而且在网上仍是同享了许多的文章写出自己的亲身阅历,那么终究这香港验血能帮忙到妈妈们么?关于妈妈们的损害大不大呢?今天我的这篇文章就是来简略的同享一下吧!希望可以来帮忙到妈妈们去了解吧!
香港验血现在在国际上仍是比较有声威的,它的准确率让它处于一个很高的方位,因此也吸引了许多人慕名而去的呢!那些同享阅历的妈妈们必定是有让她们信服的当地,便同享出来,希望可以帮忙到更多的妈妈们去了解这项技术吧!不能说是全都是差错的,也是有一些很重要的信息呢!其实,香港验血是值得去考虑的,终究人家的准确率是高达99.8%的呢!
1,去验血先了解信息。
关于验血这方面,我仍是希望妈妈们可以好好的先上网查阅一些信息啥的吧!这样会有一些帮忙的呢!要搞清楚各个安排的准确性,不能上当受骗了呢!关于医生也是要有一些了解的呢!好好的与医生先签字,这样是可以在必定程度上精约许多工作的呢!或许也是可以减少一下妈妈们的费用的呢!
2,准备好自己行囊。
在内陆的妈妈们假设要去香港的话,那也是很费劲的呢!要准备好自己的行囊啥的哦!行李也是很费劲的呢!需求好好的安排计划的呢!去香港的衣服,金钱,食用,住所等等,这些方面都是要好好的考虑一下的呢!不能太过于迷糊的哦!自己的行囊是很重要的,实在不行要和自己的老公好好协商的嗯!
3,香港验血的布景。
香港验血这项技术是非常的凶狠的,在那里都是比较有声威的呢!国内的妈妈们都是因为它的准确性高而去的吧!香港验血是有强硬的技术支撑的呢!与西方的技术相结合呢!在香港本地也是大力的支撑呢!香港可是与大陆不相同的呢!香港是可以奉告妈妈们关于胎儿的信息的呢!香港验血的布景我也就介绍这么多了,希望我的介绍可以帮忙到妈妈们哦!
香港验血是可以让妈妈们信赖的呢,准确性仍是比较高的呢!我个人认为在最大的程度上可以帮忙到妈妈们的哦!希望有条件的妈妈们可以去检验一下哦!
